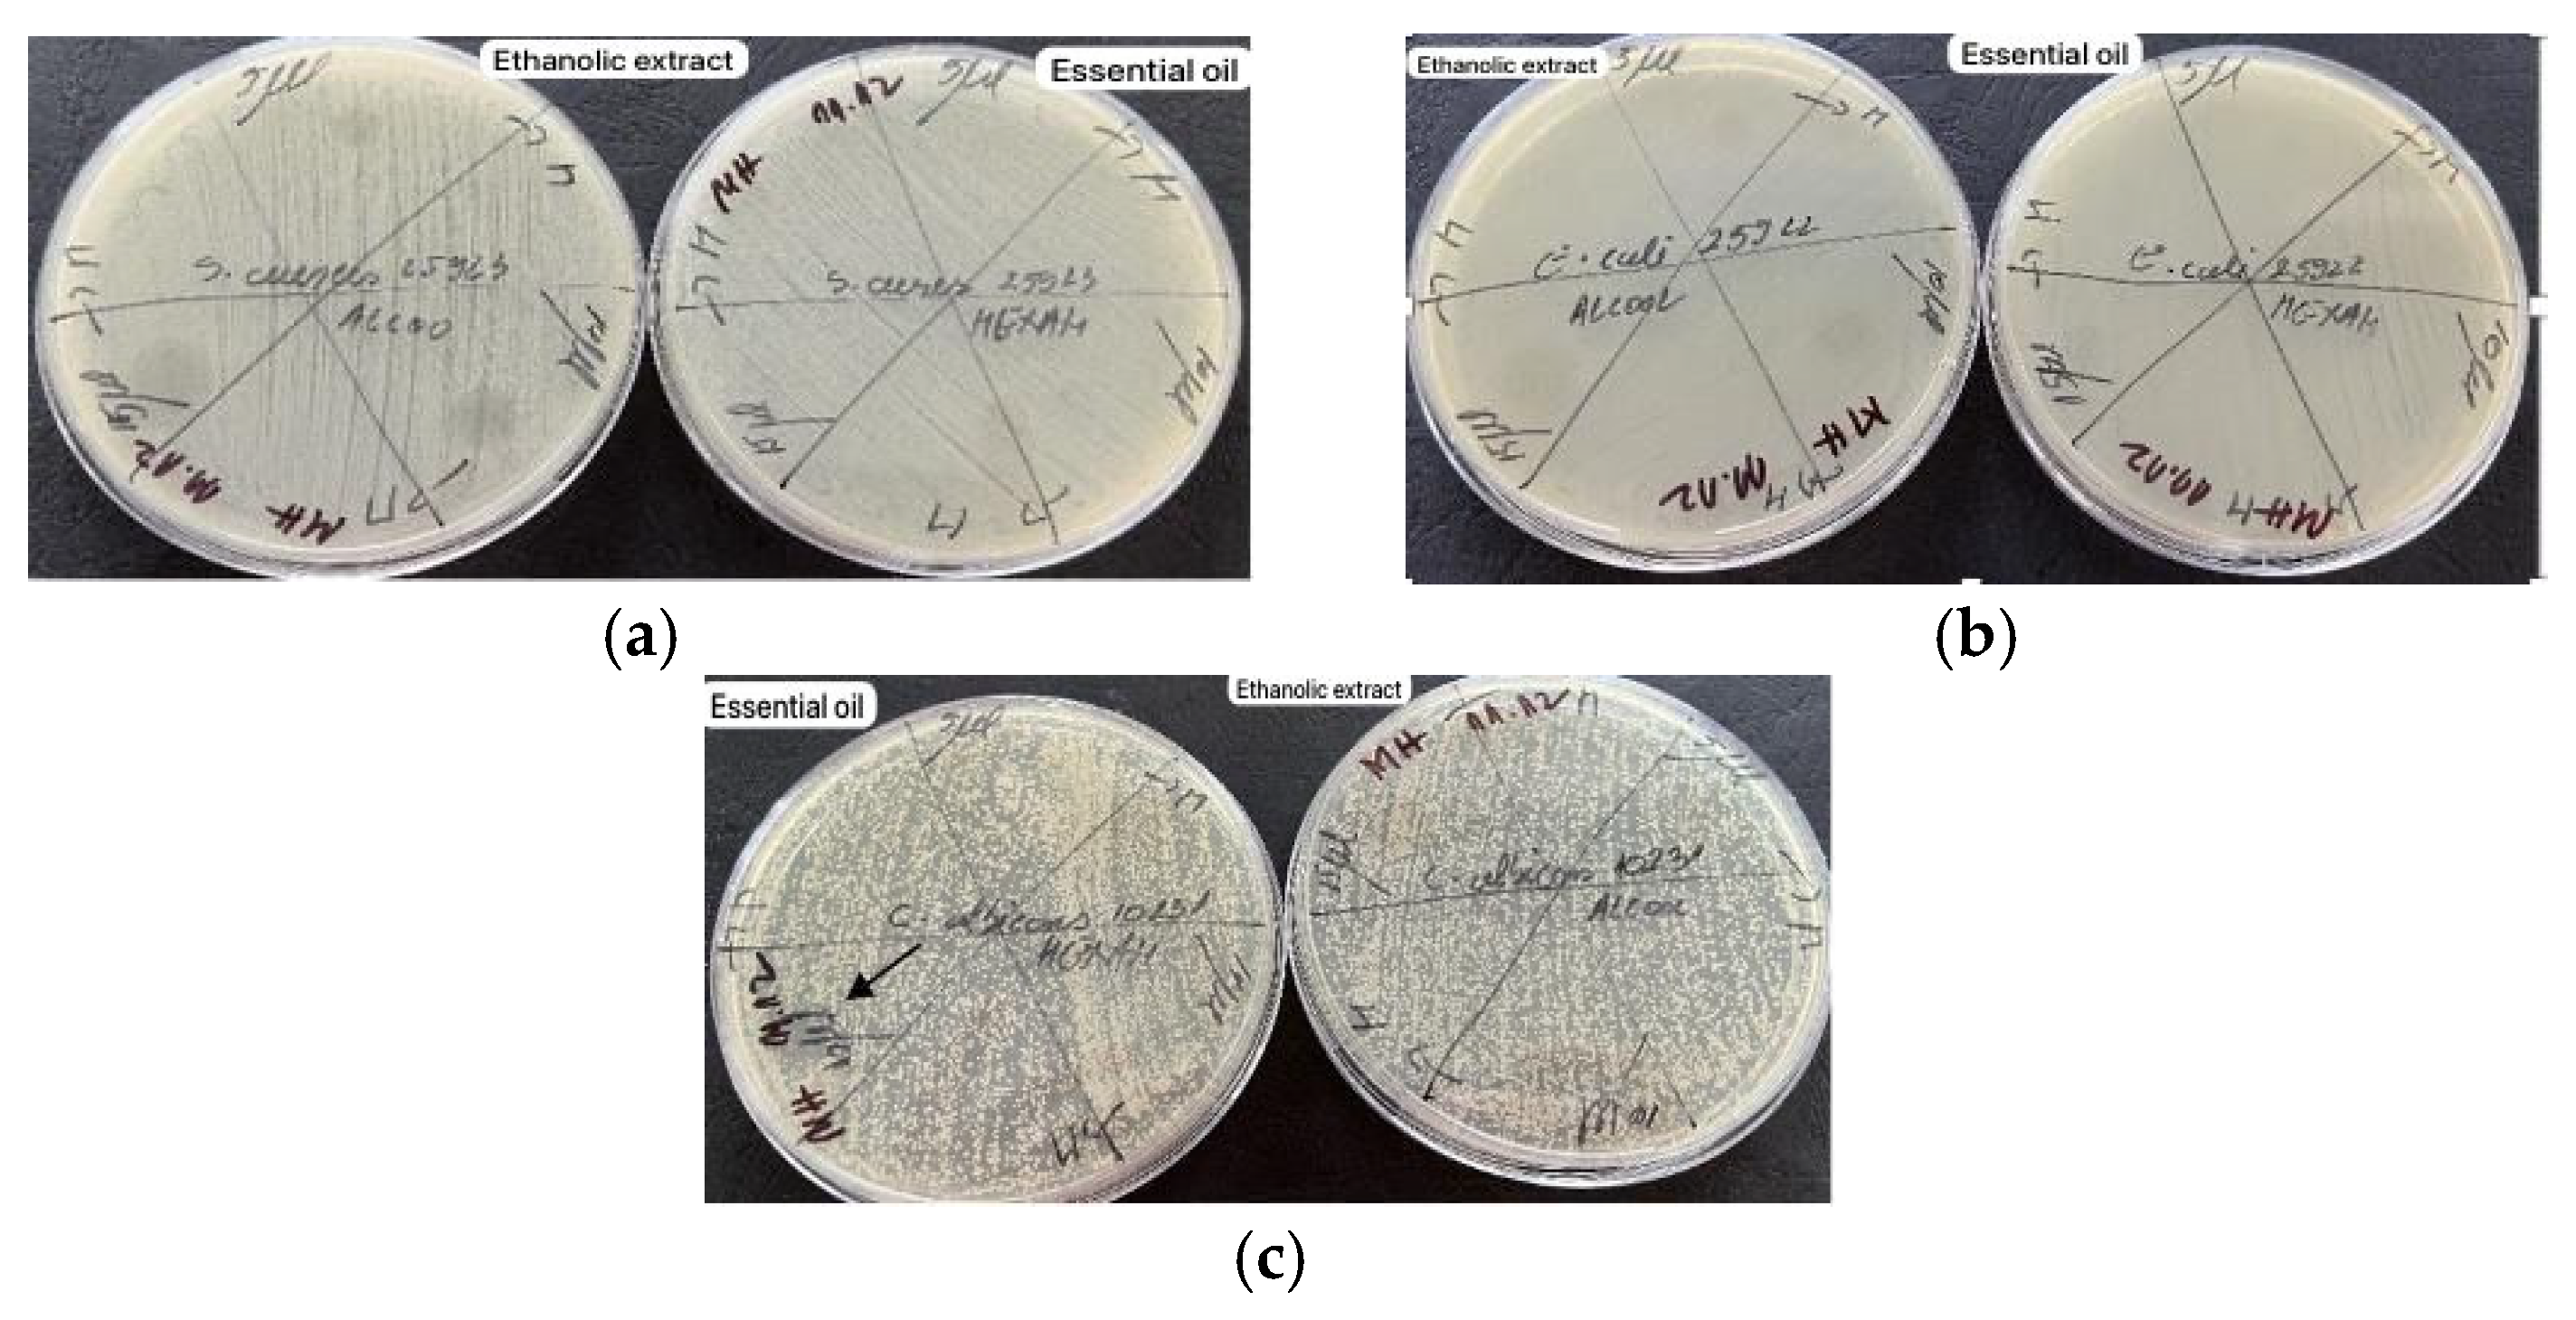
Molecules 29 02128 g003

Phytochemical Characterization, Antioxidant, and Antimicrobial Activity of the Vegetative Buds from Romanian Spruce, Picea abies (L.) H. Karst.
Abstract
1. Introduction
2. Results
2.1. Total Phenolic and Flavonoid Content
2.2. HPLC Analysis
2.3. GC-MS Analysis
2.4. Heavy Metal Detection
2.5. Essential Oil Analysis
2.6. Antioxidant Activity
2.7. Antibacterial Activity
3. Discussion
4. Materials and Methods
4.1. Plant Material and Extraction
4.2. Determination of Total Phenolic and Flavonoid Content
4.3. HPLC Analysis
4.4. Gas-Chromatographic Analysis
4.5. Heavy Metals Detection
4.6. Essential Oil Analysis
4.7. Antioxidant Activity
4.8. Antimicrobial Activity
- Preparation of Microplates: Nutrient Broth liquid culture medium was distributed in 96-well microplates under aseptic conditions, with 100 µL in each well, except for column 1, where 180 µL was distributed.
- Dispensing of Extracts: 20 µL of the extract was dispensed into each well from A1 to H1.
- Binary Serial Dilutions: Binary serial dilutions of the tested extracts were performed, up to well 10.
- Inoculation: Bacterial strains were inoculated up to well 11, with suspensions prepared in sterile physiological water (SFW) at a density of 1.5 × 105 microbial cells/mL. Wells 11 served as a bacterial growth control, while wells 12 acted as a sterility control.
- Incubation: Samples were incubated at 37 ± 0.5 °C for 22 ± 2 h to facilitate microbial growth.
- Sampling: After the incubation period, 10 µL was sampled from each well.
- Inoculation on PCA Medium: The sampled volume from each well was inoculated onto PCA agar plates.
- Final Incubation: Inoculated plates were further incubated at 37 °C for 18–24 h.
4.9. Statistical Data Processing
5. Conclusions
Supplementary Materials
Author Contributions
Funding
Institutional Review Board Statement
Informed Consent Statement
Data Availability Statement
Conflicts of Interest
References
- Mofikoya, O.O.; Eronen, E.; Mäkinen, M.; Jänis, J. Production and Characterization of Hydrothermal Extracts of the Needles from Four Conifer Tree Species: Scots Pine, Norway Spruce, Common Juniper, and European Larch. ACS Sustain. Chem. Eng. 2023, 11, 1540–1547. [Google Scholar] [CrossRef] [PubMed]
- Ilie, D.M. Păduri din România Elemente de Dendrologie şi Ecologie; Editura Universităţii “Lucian Blaga”: Sibiu, Romania, 2015; pp. 36–39. [Google Scholar]
- Jyske, T.; Järvenpää, E.; Kunnas, S.; Sarjala, T.; Raitanen, J.E.; Mäki, M.; Pastell, H.; Korpinen, R.; Kaseva, J.; Tupasela, T. Sprouts and Needles of Norway Spruce (Picea abies (L.) Karst.) as Nordic Specialty-Consumer Acceptance, Stability of Nutrients, and Bioactivities during Storage. Molecules 2020, 25, 4187. [Google Scholar] [CrossRef] [PubMed]
- Papp, N.; Purger, D.; Czigle, S.; Czégényi, D.; Stranczinger, S.; Tóth, M.; Dénes, T.; Kocsis, M.; Takácsi-Nagy, A.; Filep, R. The Importance of Pine Species in the Ethnomedicine of Transylvania (Romania). Plants 2022, 11, 2331. [Google Scholar] [CrossRef] [PubMed]
- Korecký, J.; Čepl, J.; Stejskal, J.; Faltinová, Z.; Dvořák, J.; Lstibůrek, M.; El-Kassaby, Y.A. Genetic diversity of Norway spruce ecotypes assessed by GBS-derived SNPs. Sci. Rep. 2021, 11, 23119. [Google Scholar] [CrossRef] [PubMed]
- Bianchi, S.; Kroslakova, I.; Janzon, R.; Mayer, I.; Saake, B.; Pichelin, F. Characterization of condensed tannins and carbohydrates in hot water bark extracts of European softwood species. Phytochemistry 2015, 120, 53–61. [Google Scholar] [CrossRef] [PubMed]
- Ganthaler, A.; Stöggl, W.; Kranner, I.; Mayr, S. Foliar Phenolic Compounds in Norway Spruce with Varying Susceptibility to Chrysomyxa rhododendri: Analyses of Seasonal and Infection-Induced Accumulation Patterns. Front. Plant Sci. 2017, 8, 1173. [Google Scholar] [CrossRef] [PubMed]
- Radulescu, V.; Saviuc, C.; Chifiriuc, C.; Oprea, E.; Ilies, D.C.; Marutescu, L.; Lazar, V. Chemical composition and antimicrobial activity of essential oil from shoots spruce (Picea abies L.). Rev. Chim. 2011, 62, 69–74. [Google Scholar]
- Mofikoya, O.O.; Mäkinen, M.; Jänis, J. Chemical Fingerprinting of Conifer Needle Essential Oils and Solvent Extracts by Ultrahigh-Resolution Fourier Transform Ion Cyclotron Resonance Mass Spectrometry. ACS Omega 2020, 5, 10543–10552. [Google Scholar] [CrossRef] [PubMed]
- Visan, D.C.; Oprea, E.; Radulescu, V.; Voiculescu, I.; Biris, I.A.; Cotar, A.I.; Saviuc, C.; Chifiriuc, M.C.; Marinas, I.C. Original Contributions to the Chemical Composition, Microbicidal, Virulence-Arresting and Antibiotic-Enhancing Activity of Essential Oils from Four Coniferous Species. Pharmaceuticals 2021, 14, 1159. [Google Scholar] [CrossRef]
- Gérardin, P.; Hentges, D.; Gérardin, P.; Vinchelin, P.; Dumarçay, S.; Audoin, C.; Gérardin-Charbonnier, C. Knotwood and Branchwood Polyphenolic Extractives of Silver Fir, Spruce and Douglas Fir and Their Antioxidant, Antifungal and Antibacterial Properties. Molecules 2023, 28, 6391. [Google Scholar] [CrossRef]
- Vainio-Kaila, T.; Zhang, X.; Hänninen, T.; Kyyhkynen, A.; Johansson, L.S.; Willför, S.; Österberg, M.; Siitonen, A.; Rautkari, L. Antibacterial effects of wood structural components and extractives from Pinus sylvestris and Picea abies on methicillin-resistant Staphylococcus aureus and Escherichia coli O157: H7. BioResources 2017, 12, 7601–7614. [Google Scholar] [CrossRef]
- Sipponen, A.; Kuokkanen, O.; Tiihonen, R.; Kauppinen, H.; Jokinen, J.J. Natural coniferous resin salve used to treat complicated surgical wounds: Pilot clinical trial on healing and costs. Int. J. Dermatol. 2012, 51, 726–732. [Google Scholar] [CrossRef] [PubMed]
- Co, M.; Fagerlund, A.; Engman, L.; Sunnerheim, K.; Sjöberg, P.J.; Turner, C. Extraction of antioxidants from spruce (Picea abies) bark using eco-friendly solvents. Phytochem. Anal. 2012, 23, 1–11. [Google Scholar] [CrossRef] [PubMed]
- Ul’yanovskii, N.V.; Onuchina, A.A.; Faleva, A.V.; Gorbova, N.S.; Kosyakov, D.S. Comprehensive Characterization of Chemical Composition and Antioxidant Activity of Lignan-Rich Coniferous Knotwood Extractives. Antioxidants 2022, 11, 2338. [Google Scholar] [CrossRef] [PubMed]
- Kim, E.; Kang, Y.G.; Kim, Y.J.; Lee, T.R.; Yoo, B.C.; Jo, M.; Kim, J.H.; Kim, J.H.; Kim, D.; Cho, J.Y. Dehydroabietic Acid Suppresses Inflammatory Response Via Suppression of Src-, Syk-, and TAK1-Mediated Pathways. Int. J. Mol. Sci. 2019, 20, 1593. [Google Scholar] [CrossRef]
- Eklund, P.; Raitanen, J.E. 9-Norlignans: Occurrence, Properties and Their Semisynthetic Preparation from Hydroxymatairesinol. Molecules 2019, 24, 220. [Google Scholar] [CrossRef] [PubMed]
- Gălăţanu, M.L.; Panţuroiu, M.; Sandulovici, R.C. Flavonoids: Bioactive Compunds with Anti-Cancer Properties. In Handbook of Research on Natural Products and Their Bioactive Compounds as Cancer Therapeutics; Pandurangan, A.K., Anandasadagopan, S.K., Alhumaydhi, F.A., Eds.; IGI Global: Hershey, PA, USA, 2022; pp. 297–318. [Google Scholar] [CrossRef]
- Crowell, P.L.; Elson, C.E.; Bailey, H.H.; Elegbede, A.; Haag, J.D.; Gould, M.N. Human metabolism of the experimental cancer therapeutic agent d-limonene. Cancer Chemother. Pharmacol. 1994, 35, 31–37. [Google Scholar] [CrossRef] [PubMed]
- Ceburnis, D.; Steinnes, E. Conifer needles as biomonitors of atmospheric heavy metal deposition: Comparison with mosses and precipitation, role of the canopy. Atmos. Environ. 2000, 34, 4265–4271. [Google Scholar] [CrossRef]
- Viskari, E.L.; Kössi, S.; Holopainen, J.K. Norway spruce and spruce shoot aphid as indicators of traffic pollution. Environ. Pollut. 2000, 107, 305–314. [Google Scholar] [CrossRef]
- Trimbacher, C.; Weiss, P. Norway spruce: A novel method using surface characteristics and heavy metal concentrations of needles for a large-scale monitoring survey in Austria. Water Air Soil Pollut. 2004, 152, 363–386. [Google Scholar] [CrossRef]
- Suchara, I.; Sucharova, J.; Hola, M.; Reimann, C.; Boyd, R.; Filzmoser, P.; Englmaier, P. The performance of moss, grass, and 1- and 2-year old spruce needles as bioindicators of contamination: A comparative study at the scale of the Czech Republic. Sci. Total Environ. 2011, 409, 2281–2297. [Google Scholar] [CrossRef] [PubMed]
- Påhlsson, A.M.B. Toxicity of heavy metals (Zn, Cu, Cd and Pb) to vascular plants. Water Air Soil Pollut. 1989, 47, 287. [Google Scholar] [CrossRef]
- Něsković, M.; Konjević, R.; Ćulafić, L.J. Physiology of Plants; University of Belgrade: Belgrade, Serbia; NNK International: Belgrade, Serbia, 2003; p. 387. [Google Scholar]
- Marschner, H. Mineral Nutrition of Higher Plants, 2nd ed.; Academic Press: London, UK, 1995; p. 889. [Google Scholar]
- Cheng, S. Effects of heavy metals on plants and resistance mechanisms. A state-of-the-art report with special reference to literature published in Chinese journals. Environ. Sci. Pollut. Res. Int. 2003, 10, 256–264. [Google Scholar] [CrossRef] [PubMed]
- Ferreira-Santos, P.; Genisheva, Z.; Botelho, C.; Santos, J.; Ramos, C.; Teixeira, J.A.; Rocha, C.M.R. Unravelling the Biological Potential of Pinus pinaster Bark Extracts. Antioxidants 2020, 9, 334. [Google Scholar] [CrossRef]
- Tümen, İ.; Akkol, E.K.; Taştan, H.; Süntar, I.; Kurtca, M. Research on the antioxidant, wound healing, and anti-inflammatory activities and the phytochemical composition of maritime pine (Pinus pinaster Ait). J. Ethnopharmacol. 2018, 211, 235–246. [Google Scholar] [CrossRef] [PubMed]
- Sut, S.; Maccari, E.; Zengin, G.; Ferrarese, I.; Loschi, F.; Faggian, M.; Paolo, B.; De Zordi, N.; Dall’Acqua, S. Smart Extraction Chain with Green Solvents: Extraction of Bioactive Compounds from Picea abies Bark Waste for Pharmaceutical, Nutraceutical and Cosmetic Uses. Molecules 2022, 27, 6719. [Google Scholar] [CrossRef] [PubMed]
- Nisca, A.; Ștefănescu, R.; Stegăruș, D.I.; Mare, A.D.; Farczadi, L.; Tanase, C. Phytochemical Profile and Biological Effects of Spruce (Picea abies) Bark Subjected to Ultrasound Assisted and Microwave-Assisted Extractions. Plants 2021, 10, 870. [Google Scholar] [CrossRef] [PubMed]
- Strižincová, P.; Ház, A.; Burčová, Z.; Feranc, J.; Kreps, F.; Šurina, I.; Jablonský, M. Spruce Bark—A Source of Polyphenolic Compounds: Optimizing the Operating Conditions of Supercritical Carbon Dioxide Extraction. Molecules 2019, 24, 4049. [Google Scholar] [CrossRef] [PubMed]
- Tetik, N.; Turhan, I.; Oziyci, H.R.; Karhan, M. Determination of D-pinitol in carob syrup. Int. J. Food Sci. Nutr. 2011, 62, 572–576. [Google Scholar] [CrossRef] [PubMed]
- Wu, S.; Chen, W.; Lu, S.; Zhang, H.; Yin, L. Metabolic Engineering of Shikimic Acid Biosynthesis Pathway for the Production of Shikimic Acid and Its Branched Products in Microorganisms: Advances and Prospects. Molecules 2022, 27, 4779. [Google Scholar] [CrossRef]
- Estévez, A.M.; Estévez, R.J. A short overview on the medicinal chemistry of (-)-shikimic acid. Mini Rev. Med. Chem. 2012, 12, 1443–1454. [Google Scholar] [CrossRef] [PubMed]
- Priyanka Singh Gupta, E.; Neha Mishra Mishra, P. Shikimic acid as intermediary model for the production of drugs effective against influenza virus. In Phytochemicals as Lead Compounds for New Drug Discovery; Elsevier: Amsterdam, The Netherlands, 2020; pp. 245–256. [Google Scholar] [CrossRef]
- Bao, X.; Zheng, Z.; Lv, J.; Bao, J.; Chang, S.; Jiang, X.; Xin, Y. Shikimic acid (SA) inhibits neuro-inflammation and exerts neuroprotective effects in an LPS-induced in vitro and in vivo model. Front. Pharmacol. 2023, 14, 1265571. [Google Scholar] [CrossRef] [PubMed]
- Batory, M.; Rotsztejn, H. Shikimic acid in the light of current knowledge. J. Cosmet. Dermatol. 2022, 21, 501–505. [Google Scholar] [CrossRef] [PubMed]
- Kim, M.J.; Sim, D.Y.; Lee, H.M.; Lee, H.-J.; Kim, S.-H. Hypolipogenic Effect of Shikimic Acid Via Inhibition of MID1IP1 and Phosphorylation of AMPK/ACC. Int. J. Mol. Sci. 2019, 20, 582. [Google Scholar] [CrossRef] [PubMed]
- Ozhimkova, E.V.; Korotkova, E.M.; Sulman, M.G.; Sulman, E.M.; Molchanov, V.P. Isolation of shikimic acid from Picea abies needles: The future prospects. In IOP Conference Series: Earth and Environmental Science; IOP Publishing: Bristol, UK, 2019; p. 316. [Google Scholar] [CrossRef]
- Siedlecka, A. Some aspects of interactions between heavy-metals and plant mineral nutrients. Acta Soc. Bot. Pol. 1995, 64, 265–272. [Google Scholar] [CrossRef]
- Günthardt-Goerg MSVollenweider, P.; Hermle, S.; Schulin, R. Growth and metal accumulation of young forest trees and understorey plants on contaminated topsoil: Influence of subsoil and time. Plant Soil 2019, 437, 375–395. [Google Scholar] [CrossRef]
- Buckley, T.N. The contributions of apoplastic, symplastic and gas phase pathways for water transport outside the bundle sheath in leaves. Plant Cell Environ. 2015, 38, 7–22. [Google Scholar] [CrossRef]
- Vollenweider, P.; Cosio, C.; Günthardt-Goerg, M.S.; Keller, C. Localization and effects of cadmium in leaves of a cadmium-tolerant willow (Salix viminalis L.). Part II Microlocalization and cellular effects of cadmium. Environ. Exp. Bot. 2006, 58, 25–40. [Google Scholar] [CrossRef]
- André, O.; Vollenweider, P.; Günthardt-Goerg, M.S. Foliage response to heavy metal contamination in Sycamore Maple (Acer pseudoplatanus L.). For. Snow Landsc. Res. 2006, 80, 275–288. [Google Scholar]
- Kamaitytė-Bukelskienė, L.; Ložienė, K.; Labokas, J. Dynamics of Isomeric and Enantiomeric Fractions of Pinene in Essential Oil of Picea abies Annual Needles during Growing Season. Molecules 2021, 26, 2138. [Google Scholar] [CrossRef]
- Korica, A.; Polis, O.; Spalvis, K.; Bartkevics, V. Quantitative and qualitative seasonal changes of Scots pine and Norway spruce foliage essential oils in Latvia, and the extraction dynamics thereof. Balt. For. 2015, 21, 51–58. [Google Scholar]
- Schoss, K.; Kočevar Glavač, N.; Kreft, S. Volatile Compounds in Norway Spruce (Picea abies) Significantly Vary with Season. Plants 2023, 12, 188. [Google Scholar] [CrossRef]
- Igimi, H.; Hisatsugu, T.; Nishimura, M. The use of d-limonene preparation as a dissolving agent of gallstones. Am. J. Dig. Dis. 1976, 21, 926–939. [Google Scholar] [CrossRef] [PubMed]
- Sun, J. D-Limonene: Safety and clinical applications. Altern Med. Rev. 2007, 12, 259–264. [Google Scholar] [PubMed]
- Silva, R.R.; da Silva, A.C.; Rodella, R.A.; Marques, M.O.M.; Zanuncio, A.J.V.; Soares, M.A.; Serrão, J.E.; Zanuncio, J.C.; Furtado, E.L. Limonene, a Chemical Compound Related to the Resistance of Eucalyptus Species to Austropuccinia psidii. Plant Dis. 2020, 104, 414–422. [Google Scholar] [CrossRef]
- Toffolatti, S.L.; Maddalena, G.; Passera, A.; Casati, P.; Bianco, P.A.; Quaglino, F. Role of terpenes in plant defense to biotic stress. In Biocontrol Agents Secondary Metabolites; Woodhead Publishing: Cambridge, UK, 2021; pp. 401–417. [Google Scholar] [CrossRef]
- Ros-Chumillas, M.; Garre, A.; Maté, J.; Palop, A.; Periago, P.M. Nanoemulsified D-Limonene Reduces the Heat Resistance of Salmonella Senftenberg over 50 Times. Nanomaterials 2017, 7, 65. [Google Scholar] [CrossRef] [PubMed]
- Tung, Y.T.; Huang, C.C.; Ho, S.T.; Kuo, Y.H.; Lin, C.C.; Lin, C.T.; Wu, J.H. Bioactive phytochemicals of leaf essential oils of Cinnamomum osmophloeum prevent lipopolysaccharide/D-galactosamine (LPS/D-GalN)-induced acute hepatitis in mice. J. Agric. Food Chem. 2011, 59, 8117–8123. [Google Scholar] [CrossRef] [PubMed]
- Ho, C.L.; Liao, P.C.; Wang, E.I.; Su, Y.C. Composition, and antifungal activities of the leaf essential oil of Neolitsea parvigemma from Taiwan. Nat. Prod. Communed. 2011, 6, 1357–1360. [Google Scholar] [CrossRef]
- Hui, L.M.; Zhao, G.D.; Zhao, J.J. δ-Cadinene inhibits the growth of ovarian cancer cells via caspase-dependent apoptosis and cell cycle arrest. Int. J. Clin. Exp. Pathol. 2015, 8, 6046–6056. [Google Scholar]
- Letaief, T.; Garzoli, S.; Laghezza Masci, V.; Mejri, J.; Abderrabba, M.; Tiezzi, A.; Ovidi, E. Chemical Composition and Biological Activities of Tunisian Ziziphus lotus Extracts: Evaluation of Drying Effect, Solvent Extraction, and Extracted Plant Parts. Plants 2021, 10, 2651. [Google Scholar] [CrossRef]
- Ceccarelli, I.; Fiorenzani, P.; Pessina, F.; Pinassi, J.; Aglianò, M.; Miragliotta, V.; Aloisi, A.M. The CB2 Agonist β-Caryophyllene in Male and Female Rats Exposed to a Model of Persistent Inflammatory Pain. Front. Neurosci. 2020, 14, 850. [Google Scholar] [CrossRef] [PubMed]
- Woo, J.; Yang, H.; Yoon, M.; Gadhe, C.G.; Pae, A.N.; Cho, S.; Lee, C.J. 3-Carene, a Phytoncide from Pine Tree Has a Sleep-enhancing Effect by Targeting the GABAA-benzodiazepine Receptors. Exp. Neurobiol. 2019, 28, 593–601. [Google Scholar] [CrossRef] [PubMed]
- Claeson, P.; Andersson, R.; Samuelsson, G. T-cadinol: A pharmacologically active constituent of scented myrrh: Introductory pharmacological characterization and high field 1H- and 13C-NMR data. Planta Med. 1991, 57, 352–356. [Google Scholar] [CrossRef] [PubMed]
- Salehi, B.; Upadhyay, S.; Erdogan Orhan, I.; Kumar Jugran, A.; LD Jayaweera, S.; ADias, D.; Sharopov, F.; Taheri, Y.; Martins, N.; Baghalpour, N.; et al. Therapeutic Potential of α- and β-Pinene: A Miracle Gift of Nature. Biomolecules 2019, 9, 738. [Google Scholar] [CrossRef] [PubMed]
- Suzuki, Y.; Yamane, H.; Spray, C.R.; Gaskin, P.; Macmillan, J.; Phinney, B.O. Metabolism of ent-Kaurene to Gibberellin A (12)-Aldehyde in Young Shoots of Normal Maize. Plant Physiol. 1992, 98, 602–610. [Google Scholar] [CrossRef] [PubMed]
- Lebedev, V.G.; Lebedeva, T.N.; Vidyagina, E.O.; Sorokopudov, V.N.; Popova, A.A.; Shestibratov, K.A. Relationship between Phenolic Compounds and Antioxidant Activity in Berries and Leaves of Raspberry Genotypes and Their Genotyping by SSR Markers. Antioxidants 2022, 11, 1961. [Google Scholar] [CrossRef] [PubMed]
- Tešević, V.V.; Milosavljevic, S.; Vajs, V.V.; Djordjevic, I.; Soković, M.D.; Lavadinović, V.; Novaković, M. Chemical composition and antifungal activity of the essential oil of Douglas fir (Pseudosuga menziesii Mirb. Franco) from Serbia. J. Serbian Chem. Soc. 2009, 74, 1035–1040. [Google Scholar] [CrossRef]
- Bagci, E.; Dığrak, M. Antimicrobial Activity of Essential Oils of some Abies (Fir) Species from Turkey. Flavour Fragr. J. 1996, 11, 251–256. [Google Scholar] [CrossRef]
- Kaur, G.J.; Arora, D.S. Antibacterial and phytochemical screening of Anethum graveolens, Foeniculum vulgare and Trachyspermum ammi. BMC Complement. Altern. Med. 2009, 9, 30. [Google Scholar] [CrossRef]
- Manso, T.; Lores, M.; de Miguel, T. Antimicrobial Activity of Polyphenols and Natural Polyphenolic Extracts on Clinical Isolates. Antibiotics 2021, 11, 46. [Google Scholar] [CrossRef]
- Bai, J.; Wu, Y.; Zhong, K.; Xiao, K.; Liu, L.; Huang, Y.; Wang, Z.; Gao, H. A Comparative Study on the Effects of Quinic Acid and Shikimic Acid on Cellular Functions of Staphylococcus aureus. J. Food Prot. 2018, 81, 1187–1192. [Google Scholar] [CrossRef]
- Veličkovic, D.; Liao, H.L.; Vilgalys, R.; Chu, R.K.; Anderton, C.R. Spatiotemporal Transformation in the Alkaloid Profile of Pinus Roots in Response to Mycorrhization. J. Nat. Prod. 2019, 82, 1382–1386. [Google Scholar] [CrossRef]
- Fyhrquist, P.; Virjamo, V.; Hiltunen, E.; Julkunen-Tiitto, R. Epidihydropinidine, the main piperidine alkaloid compound of Norway spruce (Picea abies) shows promising antibacterial and anti-Candida activity. Fitoterapia 2017, 117, 138–146. [Google Scholar] [CrossRef] [PubMed]
- Fonseca, J.D.; Mavrides, D.E.; Morgan, A.L.; Na, J.G.; Graham, P.A.; McHugh, T.D. Antibiotic resistance in bacteria associated with equine respiratory disease in the United Kingdom. Vet. Rec. 2020, 187, 189. [Google Scholar] [CrossRef]
- Virjamo, V.; Fyhrquist, P.; Koskinen, A.; Lavola, A.; Nissinen, K.; Julkunen-Tiitto, R. 1,6-Dehydropinidine Is an Abundant Compound in Picea abies (Pinaceae) Sprouts and 1,6-Dehydropinidine Fraction Shows Antibacterial Activity against Streptococcus equi Subsp. equi. Molecules 2020, 25, 4558. [Google Scholar] [CrossRef] [PubMed]
- Green, B.T.; Lee, S.T.; Panter, K.E.; Brown, D.R. Piperidine alkaloids: Human and food animal teratogens. Food Chem. Toxicol. 2012, 50, 2049–2055. [Google Scholar] [CrossRef]
- Singleton, V.L.; Orthofer, R.; Lamuela-Raventos, R.M. Analysis of total phenols and other oxidation substrates and antioxidants by means of Folin–Ciocalteau reagent. Methods Enzymol. 1999, 299, 152–178. [Google Scholar] [CrossRef]
- Dai, J.; Mumper, R.J. Plant Phenolics: Extraction, Analysis and Their Antioxidant and Anticancer Properties. Molecules 2010, 15, 7313–7352. [Google Scholar] [CrossRef] [PubMed]
- Agentia Natională a Medicamentului. Farmacopeea Română, X-th ed.; Editura Medicala: București, Romania, 1993; p. 335. [Google Scholar]
- European Directorate for the Quality of Medicines & HealthCare of the Council of Europe. European Pharmacopoeia, 10th ed.; Volume I; Council of Europe: Strasbourg, France, 2019; Available online: https://www.edqm.eu/en/european-pharmacopoeia-ph.-eur.-11th-edition (accessed on 27 April 2023).
- Munteanu, I.G.; Apetrei, C. Analytical Methods Used in Determining Antioxidant Activity: A Review. Int. J. Mol. Sci. 2021, 22, 3380. [Google Scholar] [CrossRef]
- M 100; Performance Standards for Antimicrobial Susceptibility Testing, 33rd ed. Clinical and Laboratory Standards Institute: Wayne, PA, USA, 2023.
- M 23; Development of In Vitro Susceptibility Test Methods, Breakpoints, and Quality Control Parameters, 6th ed. Clinical and Laboratory Standards Institute: Wayne, PA, USA, 2023.
- Ciobanu, S.C.; Predoi, D.; Chifiriuc, M.C.; Iconaru, S.L.; Predoi, M.V.; Popa, M.; Rokosz, K.; Raaen, S.; Marinas, I.C. Salvia officinalis-Hydroxyapatite Nanocomposites with Antibacterial Properties. Polymers 2023, 15, 4484. [Google Scholar] [CrossRef]

| Extract | TPC * (mg GAE/g DW) | TPC * (mg CAE/g DW) | TFC * (mg RE/g DW) |
|---|---|---|---|
| Picea abies buds | 25.32 ± 2.65 mg | 24.39 ± 1.76 mg | 10.54 ± 0.583 mg |
| Compound | Retention Time RT (min) | Phytochemical Class |
|---|---|---|
| Xylitol, 5TMS | 14.89 | polyol |
| Shikimic acid, 4TMS | 16.77 | cyclohexanecarboxylic acid |
| D-Pinitol, 5TMS | 17.11 | polyol |
| Quininic acid, 5TMS | 17.76 | cyclohexanecarboxylic acid |
| Galactopyranose, 5TMS | 18.48 | carbohydrates |
| D-Glucose, 5TMS | 20.06 | carbohydrates |
| Gluconic acid, 6TMS | 20.28 | polyhydroxycarboxylic acid |
| Metals | Concentration Range (mg/L) | R2 | LOD (mg/L) | LOQ (mg/L) |
|---|---|---|---|---|
| Cadmium | 0.001–0.005 | 0.9998 | 0.0003 | 0.001 |
| Lead | 0.01–0.05 | 0.9996 | 0.003 | 0.01 |
| Peak Name | Molecular Formula | Retention Time (min) | Relative Area (%) |
|---|---|---|---|
| Camphene | C10H16 | 5.160 | 2.36 |
| β-Pinene | C10H16 | 6.640 | 2.68 |
| δ-3-Carene | C10H16 | 8.895 | 4.32 |
| β-Myrcene | C10H16 | 10.629 | 1.63 |
| D-Limonene | C10H16 | 12.136 | 40.43 |
| β-Phelandrene | C10H16 | 12.547 | 0.77 |
| Terpinolene | C10H16 | 16.710 | 0.61 |
| Longifolene | C15H24 | 26.890 | 1.04 |
| Caryophyllene | C15H24 | 27.645 | 3.33 |
| Bornyl acetate | C12H20O2 | 27.937 | 0.61 |
| Humulene | C15H24 | 30.100 | 0.81 |
| α-Muurolene | C15H24 | 31.849 | 1.11 |
| δ-Cadinene | C15H24 | 32.746 | 9.95 |
| τ-Cadinol | C15H26O | 43.150 | 1.31 |
| τ-Muurolol | C15H26O | 43.508 | 3.37 |
| Cedranol | C15H26O | 43.814 | 0.75 |
| α-Cadinol | C15H26O | 44.504 | 12.53 |
| 13-Epimanool | C20H34O | 52.384 | 8.52 |
| ent-Kaurenal | C20H30O | 54.561 | 1.98 |
| α-Pinene | C10H16 | 54.781 | 0.63 |
| Total identified | 98.74 |
Disclaimer/Publisher’s Note: The statements, opinions and data contained in all publications are solely those of the individual author(s) and contributor(s) and not of MDPI and/or the editor(s). MDPI and/or the editor(s) disclaim responsibility for any injury to people or property resulting from any ideas, methods, instructions or products referred to in the content. |
© 2024 by the authors. Licensee MDPI, Basel, Switzerland. This article is an open access article distributed under the terms and conditions of the Creative Commons Attribution (CC BY) license (https://creativecommons.org/licenses/by/4.0/).
Share and Cite
Sandulovici, R.C.; Gălăţanu, M.L.; Cima, L.M.; Panus, E.; Truţă, E.; Mihăilescu, C.M.; Sârbu, I.; Cord, D.; Rîmbu, M.C.; Anghelache, Ş.A.; et al. Phytochemical Characterization, Antioxidant, and Antimicrobial Activity of the Vegetative Buds from Romanian Spruce, Picea abies (L.) H. Karst. Molecules 2024, 29, 2128. https://doi.org/10.3390/molecules29092128
Sandulovici RC, Gălăţanu ML, Cima LM, Panus E, Truţă E, Mihăilescu CM, Sârbu I, Cord D, Rîmbu MC, Anghelache ŞA, et al. Phytochemical Characterization, Antioxidant, and Antimicrobial Activity of the Vegetative Buds from Romanian Spruce, Picea abies (L.) H. Karst. Molecules. 2024; 29(9):2128. https://doi.org/10.3390/molecules29092128
Chicago/Turabian StyleSandulovici, Roxana Colette, Mona Luciana Gălăţanu, Luiza Mădălina Cima, Emilia Panus, Elena Truţă, Carmen Marinela Mihăilescu, Iulian Sârbu, Daniel Cord, Mirela Claudia Rîmbu, Ştefan Alexandru Anghelache, and et al. 2024. "Phytochemical Characterization, Antioxidant, and Antimicrobial Activity of the Vegetative Buds from Romanian Spruce, Picea abies (L.) H. Karst." Molecules 29, no. 9: 2128. https://doi.org/10.3390/molecules29092128
APA StyleSandulovici, R. C., Gălăţanu, M. L., Cima, L. M., Panus, E., Truţă, E., Mihăilescu, C. M., Sârbu, I., Cord, D., Rîmbu, M. C., Anghelache, Ş. A., & Panţuroiu, M. (2024). Phytochemical Characterization, Antioxidant, and Antimicrobial Activity of the Vegetative Buds from Romanian Spruce, Picea abies (L.) H. Karst. Molecules, 29(9), 2128. https://doi.org/10.3390/molecules29092128

